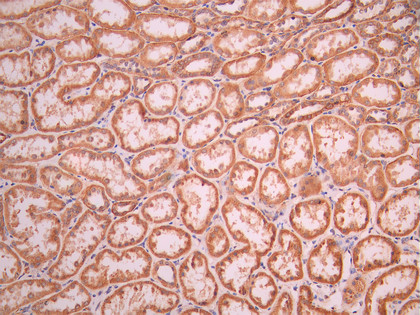

BCAM Recombinant Monoclonal Antibody
-
中文名稱:BCAM Recombinant Monoclonal Antibody
-
貨號:CSB-RA958435A0HU
-
規格:¥1320
-
圖片:
-
IHC image of CSB-RA958435A0HU diluted at 1:100 and staining in paraffin-embedded human kidney tissue performed on a Leica BondTM system. After dewaxing and hydration, antigen retrieval was mediated by high pressure in a citrate buffer (pH 6.0). Section was blocked with 10% normal goat serum 30min at RT. Then primary antibody (1% BSA) was incubated at 4°C overnight. The primary is detected by a Goat anti-rabbit polymer IgG labeled by HRP and visualized using 0.05% DAB.
-
IHC image of CSB-RA958435A0HU diluted at 1:100 and staining in paraffin-embedded human prostate cancer performed on a Leica BondTM system. After dewaxing and hydration, antigen retrieval was mediated by high pressure in a citrate buffer (pH 6.0). Section was blocked with 10% normal goat serum 30min at RT. Then primary antibody (1% BSA) was incubated at 4°C overnight. The primary is detected by a Goat anti-rabbit polymer IgG labeled by HRP and visualized using 0.05% DAB.
-
-
其他:
產品詳情
-
Uniprot No.:
-
基因名:
-
別名:Antigen identified by monoclonal antibody F8 antibody; AU antibody; Auberger B antigen antibody; B CAM cell surface glycoprotein antibody; B cell adhesion molecule antibody; B-CAM cell surface glycoprotein antibody; Basal cell adhesion molecule (Lu and Au blood groups) antibody; Basal cell adhesion molecule (Lutheran blood group) antibody; Basal cell adhesion molecule antibody; Basal cell adhesion molecule Lu and Au blood groups antibody; Basal cell adhesion molecule Lutheran blood group antibody; Bcam antibody; BCAM_HUMAN antibody; CD239 antibody; CD239 antigen antibody; F8/G253 antigen antibody; Glycoprotein 95kDa antibody; LU antibody; Lutheran antibody; Lutheran antigen antibody; Lutheran blood group (Auberger b antigen included) antibody; Lutheran blood group Auberger b antigen included antibody; Lutheran blood group glycoprotein antibody; MSK19 antibody
-
反應種屬:Human
-
免疫原:A synthesized peptide from human BCAM protein
-
免疫原種屬:Homo sapiens (Human)
-
標記方式:Non-conjugated
-
克隆類型:Monoclonal
-
抗體亞型:Rabbit IgG
-
純化方式:Affinity-chromatography
-
克隆號:1G12
-
濃度:It differs from different batches. Please contact us to confirm it.
-
保存緩沖液:Rabbit IgG in 10mM phosphate buffered saline , pH 7.4, 150mM sodium chloride, 0.05% BSA, 0.02% sodium azide and 50% glycerol.
-
產品提供形式:Liquid
-
應用范圍:ELISA, IHC
-
推薦稀釋比:
Application Recommended Dilution IHC 1:50-1:200 -
Protocols:
-
儲存條件:Upon receipt, store at -20°C or -80°C. Avoid repeated freeze.
-
貨期:Basically, we can dispatch the products out in 1-3 working days after receiving your orders. Delivery time maybe differs from different purchasing way or location, please kindly consult your local distributors for specific delivery time.
-
用途:For Research Use Only. Not for use in diagnostic or therapeutic procedures.
相關產品
靶點詳情
-
功能:Laminin alpha-5 receptor. May mediate intracellular signaling.
-
基因功能參考文獻:
- Lu expression by erythrocytes from patients with myeloproliferative neoplasms and splanchnic venous thrombosi is significantly increased compared to erythrocytes from healthy individuals PMID: 29756283
- This is the first report showing that Lu/BCAM, in the presence of its ligand laminin, is oncogenic in human urothelial cancers and may have potential as a novel therapeutic target. PMID: 28841878
- The serum levels of IL-8, MIP-1 alpha, MIP-1 beta, MMP-8, Resistin, FLRG, and BCAM were significantly higher in breast cancer patients, but LAP and TSH-beta levels were lower. PMID: 26898119
- four new alleles with coding sequence variants were identified in the LU gene PMID: 27043150
- Cytometry analysis evidenced a specific expression profile on reticulocytes of SCA infants, with notably an increased expression of the adhesion molecules Lu/BCAM, ICAM-4 and LFA-3, both in percentage of positive cells and in surface density. PMID: 26137540
- These studies revealed amino acids 720 to 1014 of CNF1 as the binding site for Lu/BCAM. PMID: 24453976
- High BCAM expression is associated with hepatocellular carcinoma. PMID: 25051049
- Adhesion of sickle reticulocytes to HC-treated endothelial cells was decreased despite the HC-derived increase of Lu/BCAM expression. PMID: 24616094
- tumor cell migration on LM-511 requires that Lu/B-CAM competitively modulates cell attachment through integrins. PMID: 24036115
- DARC and BCAM expression was associated with pathogenesis of thyroid carcinoma and correlated with clinical-pathological features. PMID: 23168236
- Glu425 in the Lu glycoprotein is required for expression of Lu7, and Ala425 is associated with the LU:-7 phenotype. This completes the molecular basis associated with all antigens known to be in the Lutheran blood group system. PMID: 23421542
- Increases in adhesion frequency provide significant evidence of the role of epinephrine in BCAM/Lu-laminin and ICAM-4-alpha(v)beta(3) bonding, and suggest mechanisms of vaso-occlusion during physical exertion in sickle cell trait. PMID: 22404936
- Aggregation of mononuclear and red blood cells through an {alpha}4{beta}1-Lu/basal cell adhesion molecule interaction in sickle cell disease PMID: 20562314
- BCAM glycoproteins are the unique erythroid receptors of laminin alpha5 chain, a major component of the extracellular matrix and are involved in several erythrocyte diseases. PMID: 20655789
- Results demonstrate that the alpha5 LG3 module is essential for the Lutheran blood group glycoprotein (Lu) binding to laminin alpha5. PMID: 12244066
- B-CAM/LU is the most critical receptor mediating adhesion to laminin under both static and flow conditions in sickle cell anemia. PMID: 14755370
- interactions of B-CAM and laminin may be involved in progression of epithelial skin tumors PMID: 15278364
- Lu mediates the adhesion of human endothelial cells to alpha5 laminins in collaboration with integrins beta(1) and alpha(v)beta(3). PMID: 16236823
- B-CAM spliceoform seems to be overexpressed by a variety of different malignant tumors and may be involved, along with other adhesion receptor proteins, in malignant transformation and tumor metastasis. (review) PMID: 16584446
- The Laminin 511/521-binding site on the Lutheran blood group glycoprotein is located at the flexible junction of Ig domains 2 and 3. PMID: 17638854
- study presents a combined modeling & small angle X-ray scattering approach that extends the structural analysis of Lu gp to all five extracellular domains & provides further insight to its interaction with laminins (Ln511 & Ln521) PMID: 18302987
- Lu/BCAM gps expressed on erythroid or on endothelial cells are involved in SS RBC-endothelium interactions & could play a role in abnormal adhesion of SS RBCs to vascular endothelium contributing to vaso-occlusive crises reported for sickle cell disease. PMID: 18514010
- the interaction of the Lu cytoplasmic tail with the cytoskeleton regulates its adhesive receptor function PMID: 18815288
- CD239 was expressed in a constitutive fashion in polycythaemia vera-derived bone marrow cells and thus a pro-thrombotic function does not seem to be mediated by increased CD239 expression alone. PMID: 18972067
- Lutheran blood group glycoprotein (Lu) is one of the proteins cleaved by MT1-MMP. PMID: 19667067
顯示更多
收起更多
-
亞細胞定位:Membrane; Single-pass type I membrane protein.
-
組織特異性:Wide tissue distribution (highest in the pancreas and very low in brain). Closely associated with the basal layer of cells in epithelia and the endothelium of blood vessel walls.
-
數據庫鏈接:
Most popular with customers
-
-
YWHAB Recombinant Monoclonal Antibody
Applications: ELISA, WB, IHC, IF, FC
Species Reactivity: Human, Mouse, Rat
-
Phospho-YAP1 (S127) Recombinant Monoclonal Antibody
Applications: ELISA, WB, IHC
Species Reactivity: Human
-
-
-
-
-